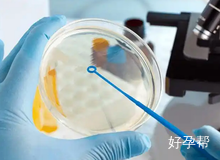
哪些情况需要做试管婴儿?哪种情况建议尽早做试管?

第 1 2 8 2 3 期
哪些情况需要做试管婴儿?哪种情况建议尽早做试管?
发布:2025-03-25 13:39:07
导语
试管婴儿技术作为一种先进的辅助生殖手段,为众多深受不孕症困扰的夫妇重新点燃了生育的希望之光。这项技术通过科学的手段,在实验室环境下实现了精子和卵子的结合与胚胎的发育,为那些自然受孕困难的夫妇提供了一个宝贵的生育机会。
好孕百科 / 生男生女 / 哪些情况需要做试管婴儿?哪种情况建议尽早做试管?

导语
试管婴儿技术作为一种先进的辅助生殖手段,为众多深受不孕症困扰的夫妇重新点燃了生育的希望之光。这项技术通过科学的手段,在实验室环境下实现了精子和卵子的结合与胚胎的发育,为那些自然受孕困难的夫妇提供了一个宝贵的生育机会。
哪些情况需要做试管婴儿?哪种情况建议尽早做试管?
试管婴儿技术作为一种先进的辅助生殖手段,为众多深受不孕症困扰的夫妇重新点燃了生育的希望之光。这项技术通过科学的手段,在实验室环境下实现了精子和卵子的结合与胚胎的发育,为那些自然受孕困难的夫妇提供了一个宝贵的生育机会。但并非所有不孕症都需要通过试管婴儿来解决,下面我们将详细探讨哪些情况下需要做试管婴儿,以及哪些情况下建议尽早考虑试管婴儿。

一、需要做试管婴儿的情况
1. 女性不孕症
输卵管疾病:输卵管阻塞、输卵管发育不全或输卵管积水等问题,会阻碍精子和卵子的相遇,使得卵子无法在体内受精。因此,这类患者需要将卵子在体外受精,待受精卵发育成胚胎后,再将胚胎移植入宫腔。
子宫内膜异位症:患有子宫内膜异位症时,往往会发生输卵管内或盆腔内粘连,导致输卵管阻塞或影响输卵管正常蠕动,也需要体外受精。
排卵功能障碍:女性卵巢水平下降、持续无排卵或排卵障碍的患者,也适合进行试管婴儿手术。
2. 男性不孕症
精子异常:男方重度的少精症、弱精子症、无精症(非真正的无精,而是由于输精管堵塞等原因),或精子不液化等,都影响怀孕。需要通过试管婴儿技术进行精子筛选,并在体外完成受精。
3. 原因不明的不孕症
男女双方都没有明显的生殖系统问题和原因,但经过反复的宫内人工授精或常规治疗方法后,仍然无法怀孕,可以考虑试管婴儿技术。
二、建议尽早做试管婴儿的情况
1. 输卵管因素导致的不孕
对于输卵管堵塞、输卵管发育不全等问题,试管婴儿技术可以有效绕过自然受孕的障碍,实现受孕。
2. 男性精子异常
严重的少精、弱精、畸形精子症,甚至无精症(但非真正的无精)的男性,自然受孕的机会较低。通过试管婴儿技术中的单精子注射(ICSI),可以将外观正常的精子直接注射到卵细胞内,提高受精率。
3. 高龄生育
女性年龄超过35岁,卵巢功能开始下降,自然怀孕变得困难。特别是40岁以上的女性,卵巢功能显著降低,卵子质量和数量减少。如果高龄备孕女性或检测结果显示卵巢功能下降,试管婴儿技术是一个有效的选择。但需要注意的是,年龄越大,试管婴儿的成功率也会相应降低。
4. 患有遗传性疾病的家庭
如果家族中有遗传性疾病史,且希望避免将疾病遗传给下一代,可以选择试管婴儿技术中的胚胎植入前遗传学诊断(PGD)或胚胎植入前遗传学筛查(PGS)。这些技术可以帮助筛选出不携带致病基因的胚胎,实现优生优育。
5. 曾生育过不健康宝宝的家庭
这类家庭再次备孕生育的宝宝患病率可能较高。借助试管婴儿技术,可以在胚胎植入前进行遗传学诊断,降低患病风险。
6. 反复流产
对于经历了多次流产的女性,试管婴儿技术可以帮助找到并解决导致流产的问题,从而提高妊娠成功率。
在面临上述问题时,建议咨询专业医生,了解自身情况,选择合适的治疗方法。如想咨询其他生育问题,联系好孕帮的医疗顾问,即将为您量身定制求子方案,从此开启希望之旅。


-
如何解开备孕疑惑,轻松好孕?
 备孕小夫妻,总是爱着急 我九月十号的预产期,闺女提前一周就发动了,在孕晚期的时候,总是希望闺女快点发动,没想到,自己在想和闺密去玩的三号这天早上五点左右就流了蛮多的分泌物,以为自己要生了,叫老公叫了他姐姐过来,我站在地板上,
我九月十号的预产期,闺女提前一周就发动了,在孕晚期的时候,总是希望闺女快点发动,没想到,自己在想和闺密去玩的三号这天早上五点左右就流了蛮多的分泌物,以为自己要生了,叫老公叫了他姐姐过来,我站在地板上, -
【我求你助】答疑会中奖名单公布啦!姐妹们快来围观吧~
 




















